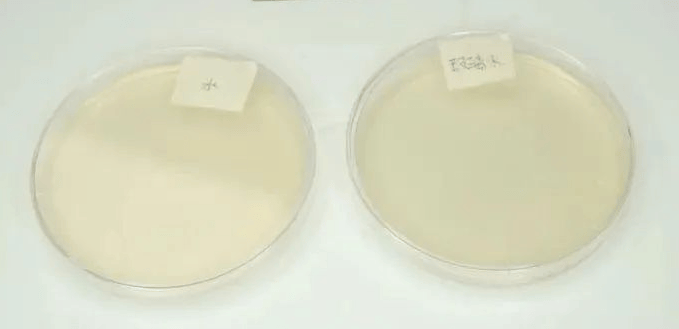
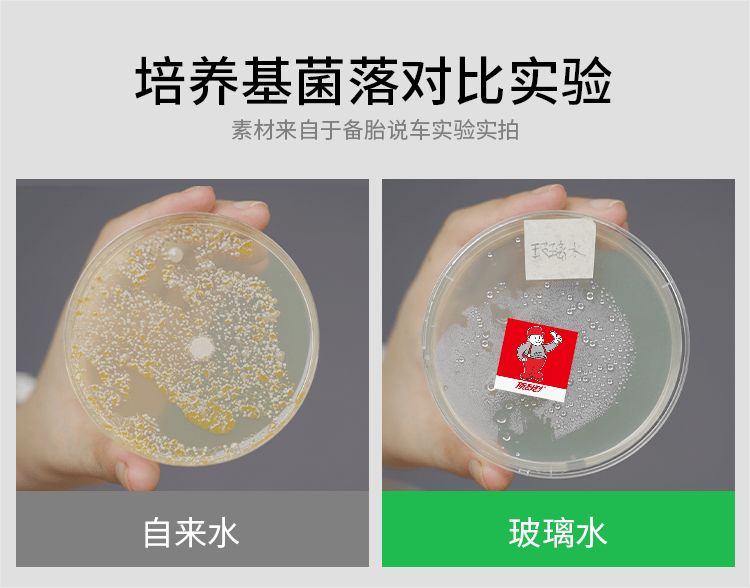

玻璃水成分不一样,效果差远了!怎么理解呢?实验来证!
1、乙醇和三乙醇胺可以处理污垢和油垢
拿顶刮刮的玻璃水给大家举例,里面的主要成分有乙醇、三乙醇胺和卡松。

先说乙醇和三乙醇胺。
乙醇是有机溶剂,溶解性很好,可以增加玻璃水对油垢、动植物胶质等污物的溶解性。三乙醇胺可以溶解油性污垢,也可以提高玻璃水的去污性能。简单理解就是,它们可以处理污垢和油垢。


(脏物模拟实验)
可以看到,如果沾上了顽固污渍,单纯用自来水清洗 ,玻璃是越刮越糊的。
而玻璃水使用以后,污垢很轻松就被刮掉了,玻璃很透亮。

不过玻璃水不是专门除油膜用的,效果有限,如果需要彻底除油膜的话建议还是购买除油膜剂,或者用家里的牙膏。
2、卡松可以杀菌,保持水壶清洁
然后再来说说卡松,它是一种杀菌剂,可以抑制细菌、真菌等微生物生长,让玻璃水壶里面保持清洁。

这个有点玄学,是英国健康防护局研究发现的。他们发现司机患一种叫军团菌病的概率是普通人的5倍,这是一种通过空气传播,由军团菌引起的疾病,病症类似肺炎,严重时甚至会死。
更深入的调查发现,之所以这种病会变成司机的“职业病”,就是因为不少司机用水代替玻璃水。
长期用水代替玻璃水,可能会使玻璃清洗系统的管路内滋生出大量的军团菌,就好像给细菌铺了个培养皿,人工养殖一样。

如果吸入这种被污染水源产生的水雾就可能致病。据统计,英国有20%的军团菌病例都是由汽车玻璃清洗系统引起的。
所以长期使用自来水代替玻璃水,可能引发疾病。而玻璃水里的乙醇等有机物除了防冻、抗腐蚀等作用之外,本身还带有一定的抑菌功能。

自来水还有其他的危害
1、自来水会滋生细菌,玻璃水壶容易脏
用顶刮刮的玻璃水,和自来水再来做个细菌培养实验。分别把玻璃水和自来水,涂到培养皿上。
3天以后就可以看到,玻璃水的培养皿上,没有菌落形成,很干净。
而自来水的培养皿上则长满了菌落。那如果是自来水加到玻璃水壶里面,长期存放使用,水壶以及管道也会变脏。
这说夸张点,就有点像抽水马桶的那个水箱一样,很脏。这样被污染的水喷出来后,玻璃不但不会很干净,被喷到的地方也会散落很多细菌,变脏。
2、析出水垢,堵塞喷水口
另外,自来水也是会析出水垢的。虽然直接堵住喷水口的情况很少,但是水垢堆积,也会影响冲洗效果。

顶刮刮的玻璃水还添加了“去离子水”的成分。去离子水,简单来说就是防止玻璃水长时间存放时产生漂浮物和沉淀。
下雨时,雨水中的铁离子、锰离子等会在玻璃上发生螯合反应,变成难溶的污垢,影响开车视线。去离子水可以抑制螯合反应,同时在玻璃上形成保护层、抑制灰尘的沉积,玻璃视线更清晰。

而且国家标准规定,乙醇类物质、水和表面活性剂为主要成分的水基型玻璃水,pH值必须在6.5到10.0之间。
我们家的玻璃水pH值在8.5左右,呈弱碱性,润滑雨刮、有效去污的同时,不会对胶条、钢片乃至车漆造成损伤。

根据检测,我们的玻璃水符合国标《GB/T23436-2009 汽车风窗玻璃清洗液》的专业标准,效果好,放心用。
顶刮刮用七点科技破局传统玻璃水功能单一和效果一般的难题!不仅润滑去污效果好,还采用安全配方,经过质量检测合格,朋友们使用起来舒心、放心。
1.医用级纯去离子水净化
50层精密过滤无杂质,从源头杜绝喷孔堵塞!
2. 纳米靶向去污因子
专攻尾气油膜凝胶,5秒乳化顽固污渍!
3. 独创橡胶活化剂,胶条寿命提升50%!
4.刮拭噪音降低70dB!经278款车型严苛验证!
5.PH值智能锁存6.8-7.2,金属/橡胶/车漆0腐蚀!
6.刮拭不留痕,却留桂花香!瑞士香氛微胶囊技术,连汪星人都迷恋的清新!
7.-30℃极寒不冻结,45℃酷暑不失效!覆盖中国全境气候版图!
如此七重科技加持,不仅让玻璃刮得更干净,也在于保护雨刮胶条和前档密封胶条,更在于保护玻璃水箱少受腐蚀伤害!让爱车拥有更好的行车视野的同时,也能顾忌到配件的使用寿命!





